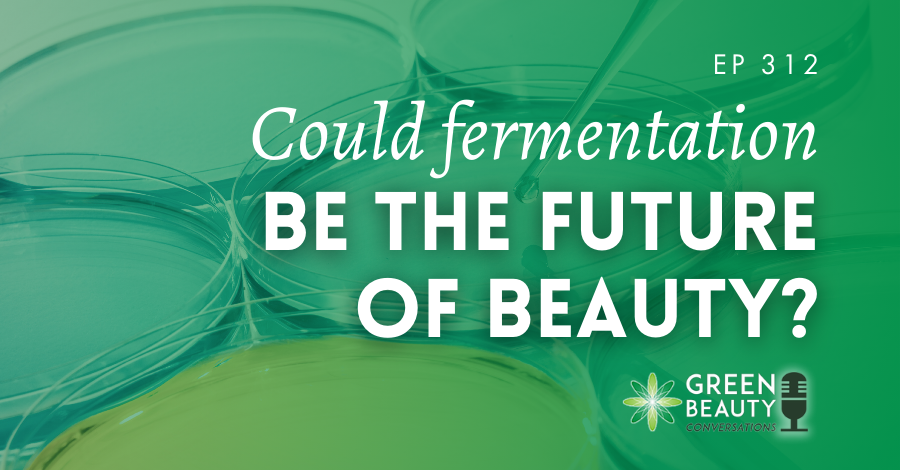
Could fermentation shape the future of beauty? Discover how microbes, biotech oils and ancient fermentation processes could challenge beauty’s plant-based assumptions.

Study Online to Become an Organic Formulator
learn more—sign up for our free e-course
Welcome to Formula Botanica

We are the leading online teaching institution for organic formulation and indie beauty entrepreneurship and we are on a mission to teach the world to formulate. We empower our students with the skills to change their lives through organic skincare and haircare. Formulating organic cosmetics with plants, flowers and herbs is an amazing, empowering skill that anyone can learn. Let us teach you how to become a formulator.
We teach award-winning online courses
Community
500,000+
Students
22,000+
Countries
193
Courses
4
5-Star Reviews
2000+
Blogs
700+
Learn to Formulate At Home
With our Award Winning Online Learning Courses
Empower yourself by becoming a professional organic skincare formulator and create beautiful botanical lotions, serums and balms to use yourself or to sell. Become part of the global green beauty movement, embracing naturals, wellness and sustainability. Enrol with Formula Botanica to receive an online education in organic skincare and haircare formulation.
We Teach the Complete Package
So you can confidently start your own organic skincare brand anywhere in the world.

Our graduates go the distance
Graduate Highlights
Our thousands of graduates lead the global green beauty movement. Their customers love their beautiful botanical serums, balms, toners, cleansers and lotions. You too can create an indie beauty business that impacts on the world around you, creates a life you love and teaches people about the benefits of natural ingredients.
Meet More Graduates
Learning Technologies Awards

accredited: Open and Distance Learning

Founded in 2012

CEW Digital Achiever Award
The Global Organic Beauty Industry will be worth $54bn by 2027.
Will you be part of it?
Sign up for our free e-courseOur Latest Content
Curious about our courses?
Try our free video training
The mainstream beauty industry would have you believe that you need to be a chemist to formulate your own skincare, but nothing could be further from the truth. Sign up now for our free mini e-course and learn how to become an organic skincare formulator.
Sign Up Now